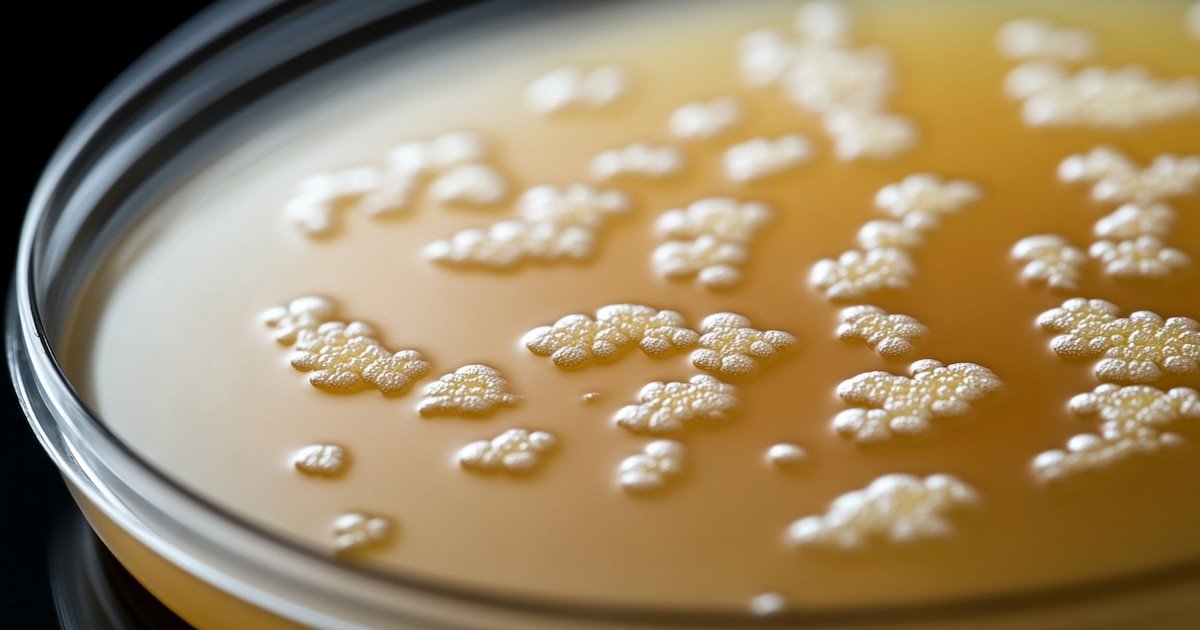

INTERNACIONAL
Después de medio siglo, un antibiótico olvidado emerge como posible solución contra superbacterias letales
Químicos de la Universidad de Warwick y la Universidad de Monash identificaron un antibiótico con una potencia y eficacia cien veces mayor que otros frente a bacterias resistentes a múltiples fármacos. El hallazgo surge en respuesta a la necesidad de nuevas terapias frente a infecciones hospitalarias graves, que representan se cobran más de un millón de vidas al año.
El antibiótico, denominado pre-metilenomicina C lactona, demostró elevada actividad incluso contra patógenos como Staphylococcus aureus resistente a meticilina (MRSA) y Enterococcus resistente a vancomicina (VRE), bacterias que figuran entre las más peligrosas según organismos internacionales de salud.
La investigación fue desarrollada por el equipo de la Alianza Monash-Warwick Contra las Amenazas de Superbacterias Emergentes. Según el Journal of the American Chemical Society, la Organización Mundial de la Salud y otros organismos advirtieron que la resistencia a los antimicrobianos sigue creciendo mientras escasean los nuevos antibióticos en desarrollo, en parte por el elevado coste y la baja rentabilidad para la industria farmacéutica.

El estudio pone de relieve una estrategia novedosa: explorar los intermediarios químicos presentes en la biosíntesis de compuestos naturales, un área poco explotada en comparación con la búsqueda tradicional de antibióticos en nuevas fuentes biológicas.
De acuerdo con el profesor Greg Challis, codirector del estudio y miembro del Departamento de Química de la Universidad de Warwick, el nuevo compuesto se hallaba como intermediario natural durante la producción de metilenomicina A, un antibiótico descubierto hace cincuenta años.
Gracias a la eliminación de determinados genes que intervienen en la ruta biosintética, los científicos lograron aislar dos intermediarios antes desconocidos, entre ellos la pre-metilenomicina C lactona. Ambos demostraron tener mayor poder antibacteriano que la metilenomicina A tradicional.

En las pruebas de laboratorio, la pre-metilenomicina C lactona superó a la metilenomicina A en eficacia por un margen de cien veces, en particular frente a bacterias de tipo Gram positivo. El compuesto resultó especialmente potente contra Staphylococcus aureus y Enterococcus faecium, responsables de infecciones difíciles de tratar en hospitales.
La doctora Lona Alkhalaf, codirectora del equipo, subrayó que el hallazgo resultó inesperado, ya que Streptomyces coelicolor, la bacteria productora, es bien conocida por la comunidad científica y se estudia desde la década de 1950. Los investigadores concluyeron que el propio microorganismo pudo haber evolucionado para fabricar variantes menos activas a lo largo del tiempo, lo que sugiere la existencia de mecanismos biológicos complejos detrás del cambio de compuestos.
Uno de los puntos destacados del estudio consiste en la resistencia bacteriana. El equipo sometió Enterococcus a condiciones comunes que suelen inducir resistencia a antibióticos convencionales, como la vancomicina, sin observar que el nuevo compuesto perdiera efectividad. La OMS reconoce a las bacterias resistentes a la vancomicina como prioridad máxima para el desarrollo de nuevos tratamientos, debido al riesgo que implican en servicios de salud y cuidados intensivos.

La investigación ofrece, además, un procedimiento sintético viable para producir el compuesto a escala. Según el profesor David Lupton, de la Universidad de Monash, la síntesis controlada permitirá crear variantes y estudiar en detalle la relación entre estructura y actividad. Esta capacidad abre la puerta a modificaciones orientadas a optimizar la eficacia y seguridad del antibiótico antes de ensayarlo en modelos más avanzados.
El siguiente paso para la pre-metilenomicina C lactona será la validación en estudios preclínicos, donde se evaluará su comportamiento en organismos completos y su seguridad para uso en seres humanos. De acuerdo con los autores, la estructura sencilla del compuesto y su método de producción eficiente constituyen ventajas comparativas para la investigación y la eventual fabricación industrial del medicamento.
La aparición de antibióticos totalmente nuevos se considera fundamental en el contexto de la crisis mundial por la resistencia a antimicrobianos. A nivel global, infecciones por bacterias multirresistentes causan un alto número de muertes cada año y significan un reto creciente para los sistemas de salud.

La posibilidad de descubrir fármacos potentes en rutas hasta ahora desestimadas, como los intermediarios biosintéticos, sugiere un cambio de paradigma en la búsqueda de antibióticos. De acuerdo con los científicos citados por Science Daily, la investigación demuestra el valor de revisar compuestos previamente considerados menos relevantes y de reforzar la colaboración internacional en la lucha contra las superbacterias.
Así, la pre-metilenomicina C lactona emerge como un candidato prometedor por su acción potente, su aparente capacidad de evitar la resistencia bacteriana y la viabilidad de su síntesis a gran escala.
Si los ensayos futuros confirman estas ventajas, el compuesto podría contribuir de manera decisiva al tratamiento de infecciones graves y frenar la amenaza global que plantean las bacterias resistentes a múltiples fármacos.
microbios
INTERNACIONAL
Elecciones en Nueva York: en un enorme revés para Trump, Zohran Mamdani se anotó un contundente triunfo
INTERNACIONAL
Economic anxiety keys Dem sweep in high-stakes races as left leverages voter frustration

NEWYou can now listen to Fox News articles!
Democrats claimed victory in a trio of high-stakes elections that largely focused on economic anxiety and affordability issues.
New Jersey Democratic Rep. Mikie Sherrill defeated Republican gubernatorial candidate Jack Ciattarelli in the New Jersey governor’s race, while former Democratic Rep. Abigail Spanberger defeated Republican challenger Winsome Earle-Sears in the Virginia gubernatorial race. In the Empire State, Socialist New York City mayoral candidate Zohran Mamdani claimed victory over former New York Gov. Andrew Cuomo, who ran as an independent, and Republican Curtis Sliwa.
The three sweeps come as Republicans worked to make inroads in the historically liberal or left-leaning jurisdictions, including campaigning on lowering taxes.
In all three elections, the economy and affordability were top concerns, according to polling data, with the liberal candidates leaning into blaming the White House for economic anxiety.
TRUMP LOOMS LARGE OVER KEY ELECTION DAY 2025 CONTESTS DESPITE NOT BEING ON BALLOT
New York City Democratic mayoral nominee Zohran Mamdani speaks during an interview on Fox News’ «The Story with Martha MacCallum,» Oct. 15, 2025, in New York City. (Evan Agostini/Invision/The Associated Press)
In New Jersey, voters reported that the state’s notoriously high taxes and the economy were their top issues heading into the polling stations, according to Fox News Voter Poll data. In Virginia, half of voters reported that the economy was their top issue, more than double the number who reported healthcare as their top concern, according to Fox polling data.
In New York City, affordability was by far voters’ top concern, according to Fox News Voter Poll data, with Mamdani notching a significant win over his challengers. Mamdani ran on policies such as city-run groceries to lower food costs, eliminating bus fares, implementing rent freezes on rent-stabilized units and other affordable housing proposals.
Voters responded by voting for Democrats following President Donald Trump’s decisive win over former Vice President Kamala Harris just more than a year ago in a federal election that also focused on the economy amid spiraling inflation woes.

Virginia Democratic gubernatorial candidate, former Rep. Abigail Spanberger celebrates as she takes the stage during her election night rally at the Greater Richmond Convention Center Nov. 4, 2025. (Win McNamee/Getty Images)
Trump and other conservatives have railed against Mamdani as a «communist» who threatens New York City’s massive economy and a symbol of American capitalism, while left-wing supporters have championed he will ease the cost burden on residents facing sky-high rent, taxes and food costs.
TRUMP IGNORES ELECTIONS AS DEMOCRATS STUMBLE ON THE WAY TO LIKELY VICTORIES
«Zohran Mamdani, a 100% Communist Lunatic, has just won the Dem Primary, and is on his way to becoming Mayor,» Trump wrote on Truth Social in June. «We’ve had Radical Lefties before, but this is getting a little ridiculous. He looks TERRIBLE, his voice is grating, he’s not very smart.»
The trio of high-profile Democrats who won their elections campaigned in part against Trump administration policies and affordability woes.

Rep. Mikie Sherrill, Democratic gubernatorial candidate for New Jersey, checks-in to cast her ballot at a polling location inside Hillside Elementary School in Montclair, New Jersey, Nov. 4, 2025. (John Lamparski/Bloomberg via Getty Images)
«Donald Trump needs to answer directly to Virginians on why he is actively cutting Virginia jobs and hurting the Virginia economy,» Spanberger said in October. «The Trump Administration has taken a sledgehammer approach to governing that has hurt Virginia’s workers, businesses, and economy.»
Sherrill pitched the current economy as a «catastrophe,» including claiming Trump’s tariffs would be disastrous.
DEMOCRAT IN KEY GOVERNOR RACE KEEPS DISTANCE FROM NYC’S MAMDANI
«Donald Trump just implemented the biggest tax increase in my lifetime — an economic catastrophe for New Jersey families,» Sherrill said in April as Trump announced increased tariffs on foreign nations. «This will raise costs to the tune of almost $4,000 per year, and many companies have already announced layoffs. No wonder the Wall Street Journal called it the ‘dumbest trade war in history.’»
New Jersey, a historically deep blue state, was viewed as the most likely to potentially flip red after the 2024 federal election showed Trump made inroads with Garden State voters, including flipping five counties to the GOP.

President Donald Trump speaks before signing an executive order barring transgender female athletes from competing in women’s or girls’ sporting events, in the East Room of the White House, Wednesday, Feb. 5, 2025, in Washington. (Alex Brandon/The Associated Press)
Following Spanberger’s win Tuesday, she celebrated that she will reinvigorate the Old Dominion State’s economy.
«Virginia chose pragmatism over partisanship,» Spanberger said. «We chose our commonwealth over chaos.»
CLICK HERE TO GET THE FOX NEWS APP
«You all chose leadership that will focus relentlessly on what matters most — lowering costs, keeping our communities safe and strengthening our economy for every Virginian,» she said.
Trump responded to the Democrat wins Tuesday with a quote from pollsters that the ongoing government shutdown was partially due to the Republican losses.
«‘TRUMP WASN’T ON THE BALLOT, AND SHUTDOWN, WERE THE TWO REASONS THAT REPUBLICANS LOST ELECTIONS TONIGHT,’ according to Pollsters,» Trump posted on Truth Social.
new jersey,economy,virginia,new york,donald trump
INTERNACIONAL
Zohran Mamdani: quién es el inmigrante musulmán izquierdista que revolucionó Nueva York y ganó la alcaldía

Nueva York eligió a Zohran Mamdani como su alcalde, este martes. Con el 88% escrutado, el legislador de 34 años obtenía el 50,3% de los votos, seguido por Cuomo (41,6%) y Sliwa (7%).
Es una victoria para el ala progresista del Partido Demócrata. Ahora, Mamdani debe navegar las interminables demandas de la ciudad más grande de Estados Unidos y cumplir con promesas de campaña ambiciosas.
Leé también: Las fábricas de EE. UU. enfrentan el reto de encontrar miles de empleados
Zohran Mamdani: un insólito adversario de Trump en Nueva York
Joven, sin gran experiencia política, inmigrante africano, musulmán, declarado “socialista” y marcadamente pro-palestino. Zohran Mamdani, el inesperado ganador de la interna del Partido Demócrata y ahora electo alcalde, revolucionó el tablero político de Nueva York, una de las ciudades más progresistas de los Estados Unidos.
Mamdani es la antítesis de todo lo que representa hoy Donald Trump. Pero sus posturas radicales, con las que capturó la atención del voto joven y migrante, comienzan a asustar al ala moderada o más inclinada a la derecha del partido.
Sus propuestas políticas parecen sacadas del manual de la izquierda latinoamericana: congelamiento de alquileres, transporte y jardines maternales gratuitos, dignidad para los trabajadores y una serie de ideas de elevado perfil social, como la creación de supermercados populares administrados por la alcaldía, que llevaron al presidente a calificarlo de «lunático comunista 100%“. Zohran Mamdani ganó la interna demócrata (Foto: REUTERS/David ‘Dee’ Delgado)
Una verdad política implacable sostiene que el ganador de la interna demócrata neoyorquina tiene asegurado su acceso a la alcaldía. Los demócratas suelen derrotar con facilidad a los republicanos en esta ciudad cosmopolita y que le dio la espalda a Trump en las últimas elecciones presidenciales. La diferencia suele ser de 6 a 1 a favor de los demócratas sobre sus rivales republicanos.
A simple vista, Mamdani partía como favorito para las elecciones locales. Pero había una luz roja encendida que titila en su camino. Su vehemente posicionamiento a la izquierda y con un respaldo firme a la causa palestina, generó una enorme desconfianza en el propio electorado demócrata inclinado hacia la derecha del partido. Se estima que en la ciudad viven unos 960.000 miembros de la comunidad judía, el 12% de la población neoyorquina que mira con absoluto estupor la adhesión de Mamdani a la campaña “Free Palestine”.
Leé también:Tras el cese el fuego con Irán, Israel se concentra en la Franja de Gaza y negocia un acuerdo con Hamas
¿Por qué un radical de izquierda ganó la interna demócrata?
Mamdani ganó las internas, y ahora la alcaldía, porque supo llegar a los jóvenes con sus propuestas para abaratar los carísimos alquileres que se cobran en la ciudad. Además, captó la atención de las comunidades latinas, con populares videos en español en redes sociales en los que él mismo se presentó como migrante en momentos en que decenas de miles de hispanos son deportados a sus países de origen.
Pero también les habló a los votantes en urdú, el idioma que hablan la mayoría de los migrantes indios y paquistaníes, sin descuidar la campaña en inglés dirigida a las clases medias a la que le cuesta cada vez más quedarse a vivir en la ciudad por los elevados costos de los alquileres. A los ricos solo les prometió que le cobraría más impuestos. En síntesis, supo forjar una nueva coalición política multirracial.
Leé también: Benjamin Netanyahu analiza convocar a elecciones anticipadas en Israel tras el anuncio del cese el fuego
“Mamdani parecía estar en todas partes”, resumió la columnista del Washington Post, Karen Tumulty. En un artículo de opinión publicado en junio, escribió que el joven dirigente de origen ugandés “identificó correctamente” los problemas que hacen cada vez más inaccesible vivir en esta ciudad, más allá de que “sus políticas pueden no ser la solución» a la crisis.
“Lo más importante que los demócratas del establishment deberían aprender de Mamdani es la lección que ofrece al abordar lo que probablemente sea el mayor problema del partido: reconectarse con los votantes más jóvenes”, indicó Tumulty.
Para la analista política, “entrar en pánico por un candidato que se autodenomina socialista no es la solución. En cambio, los demócratas deberían analizar detenidamente su propia imagen y comprender por qué, en lugar de mirar hacia el futuro, siguen presentando figuras imperfectas e inaceptables de un pasado no tan glorioso”, afirmó.
Pero el fenómeno Mamdani parece ser solo local. En general, Nueva York suele tener un ecosistema político propio. Sus alcaldes nunca llegan a tener una gran proyección nacional, como les sucedió por ejemplo a Rudy Giuliani, Mike Bloomberg o Bill de Blasio.
Estados Unidos, Elecciones, Nueva York
CHIMENTOS3 días agoPaula Robles rompió el silencio tras las amenazas de muerte a Juanita Tinelli, su hija: “Hay otro mundo en el que sí tenemos posibilidades”
CHIMENTOS3 días agoLamine Yamal contó toda la verdad sobre las infidelidades a Nicki Nicole y fue tajante: “Todo lo que está saliendo no tiene nada que ver”
POLITICA3 días agoTras los cambios de Gabinete, Milei viaja a Miami para participar de una cumbre global junto a Trump












